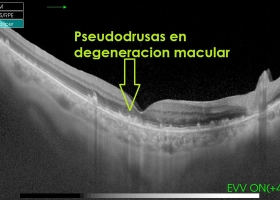
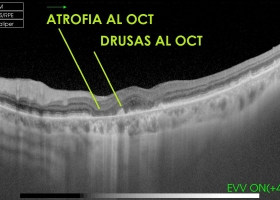
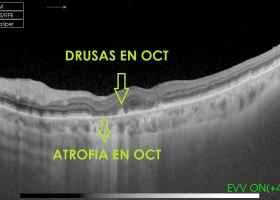
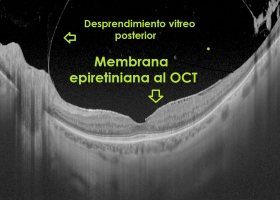

Retina y Vítreo
La RETINA formada básicamente por varias capas de neuronas interconectadas mediante sinapsis.

La retina es la pared que recubre al ojo internamente, la luz que llega a la retina es convertida en una serie de impulsos los cuales viajan a través del nervio óptico hacia la corteza visual quien traduce estos impulsos en imágenes.
La macula es la porción de la retina encargada de la visión central, nítida y definida, existen muchas enfermedades que pueden afectar la macula y alterar su visión central.
ENFERMEDADES RETINIANAS
- DMRE +
- Retinopatía Diabética +
- Desprendimiento del Vítreo Posterior (Moscas Volantes) +
- Miopía Degenerativa +
- Oclusiones Venosas Retinianas +
- Desprendimiento de Retina +
DMRE +
Descripción +
Degeneración Macular Relacionada con la Edad (DMRE)
Es una enfermedad que afecta principalmente a la macula, al presentarse afecta la visión central, la cual es necesaria para conducir automóviles, leer un libro o reconocer caras.
La DMRE no causa una pérdida total de la visión ya que el resto de la retina no se afecta, preservando entonces la visión periférica. (a los lados)
Tiene dos formas de presentación: Seca y Húmeda.
Síntomas +
- Visión borrosa
- Zona borrosa o faltante en el centro de la visión
- Las líneas rectas pueden verse onduladas o distorsionadas
Causas +
- Edad: Se presenta usualmente en personas mayores de 60 años. (Este es el principal factor de riesgo)
- Historia familiar (Genética):
- Cigarrillo: Se asocia en gran medida a la aparición de DMRE
Tratamiento +
Forma Húmeda:
- Inyecciones intraoculares: La forma húmeda puede tratarse con medicamentos inyectados dentro del ojo (Anti VEGF).
- Laser
- Forma Seca: No hay una terapia específica para el tratamiento de esta forma de DMRE, se considera el uso de medidas como utilización de gafas protectoras para el sol, consumo de multivitamínicos y rehabilitación visual. En el momento hay diferentes estudios evaluando diferentes modalidades de tratamiento.
Retinopatía Diabética +
Descripción +
Son las manifestaciones oculares que la persona con diabetes puede presentar en algún momento de su enfermedad y que pueden causar una pérdida severa de la visión y en algunos casos la ceguera.
Síntomas +
Es posible tener retinopatía diabética y no presentar ningún síntoma especialmente en los estadios más tempranos de la enfermedad.
A medida que la enfermedad progresa algunos de los síntomas que se presentan son:
- Puntos, manchas o líneas flotantes en su visión (miodesopsias)
- Visión borrosa
- Áreas oscuras o vacías en su visión, entre otras
- No espere presentar ningún síntoma, asegúrese de tener un examen del fondo de ojo con la pupila dilatada por lo menos una vez al año y desde el momento del diagnóstico.
Causas +
El mal control metabólico, específicamente cifras de glucemia (Azúcar) elevados en sangre, Hipertensión arterial, dislipidemia (Aumento de Colesterol y Triglicéridos) obesidad y mayor tiempo de diagnóstico de Diabetes son los principales factores de riesgo para presentar Retinopatía diabética.
Tratamiento +
Existen diferentes formas de tratar la Retinopatía diabética de acuerdo al estadio y a la presencia de complicaciones. Entre estas esta la terapia con láser, Inyecciones intravitreas de diferentes tipos de medicamentos como los Antivegf, esteroides. Vitrectomia Pars plana si es el caso.
Desprendimiento del Vítreo Posterior (Moscas Volantes) +
Descripción +
Se manifiestan como puntos, líneas, partículas, telarañas o moscas volantes que se mueven en el campo visual con el movimiento de los ojos. La mayoría de estos se producen por cambios degenerativos ocurridos en el vítreo (sustancia semejante a la gelatina) dentro del ojo, el cual con el paso de los años se vuelve líquido. En la mayoría de los casos no están asociados a problemas oculares serios pero en algunos casos pueden llevar a desprendimiento de retina.
Síntomas +
La aparición súbita de nuevas moscas volantes o especialmente si se asocian a flashes de luz o pérdida de visión periférica puede ser indicativo de daño grave en la retina como desgarros con o sin desprendimiento de la misma por lo que es aconsejable la evaluación inmediata por un oftalmólogo. Si esto se produce, incluso el esperar pocos días puede resultar en perdida permanente de la visión.
Causas +
- Envejecimiento
- Traumas Oculares
- Inflamación Intraocular
- Diabetes
- Post Fotocuagulación Laser
Tratamiento +
- Lo más importante es una evaluación detallada del fondo de ojo por el oftalmólogo.
- No existe un tratamiento específico para esta condición
- Algunos recomiendan la utilización de láser para romper las condensaciones vítreas, pero no existe evidencia comprobada de que este tratamiento sea efectivo.
- Vitrectomia.
Miopía Degenerativa +
Oclusiones Venosas Retinianas +
Descripción +
Las oclusiones venosas son la segunda causa más común de enfermedad vascular retiniana, después de la retinopatía diabética.
Síntomas +
La presentación más común es disminución de visión, no dolorosa de un ojo, metamorfopsias (distorsión de las imágenes), defectos en el campo visual.
La principal causa de disminución de la visión es el edema macular (acumulo de líquido en la macula) y en estadios más tardíos puede presentarse complicaciones mayores como Glaucoma neo vascular (aumento de la presión ocular) Hemorragia vítrea, Desprendimiento de retina.
Causas +
- Las principales causas para la aparición de oclusiones venosas son:
- Hipertensión arterial mal controlada (principal causa)
- Diabetes
- Aumento de colesterol y/o Triglicéridos
- Edad
- Inyección de esteroides Intravitreos: como la Traimcinolona ( Kenalog), Dexametasona, Dexametasona por medio de implante intravitreo de liberación sostenida (Ozurdex)
- Presencia de neo vasos en iris o en menor frecuencia en retina: en estos casos se debe realizar una Fotocoagulación retiniana con láser.
Tratamiento +
- Evaluación con medico clínico ( Internista, cardiólogo)
- En caso de presentarse edema macular los métodos de tratamiento más frecuentemente utilizados en la actualidad son:
- Medicamentos AntiVEGF: Como son el Avastin (Bevacizumab), Lucentis (Ranibizumab), Eylia( Aflibercept)
- Esteroides: Traimcinolona, Ozurdex.
Desprendimiento de Retina +
Descripción +
El desprendimiento de retina se considera una emergencia médica. El diagnóstico y tratamiento oportuno de esta condición pueden salvar su visión, si por algún motivo sospecha de un desprendimiento de retina debe acudir inmediatamente a un oftalmólogo.
Síntomas +
Usualmente un desprendimiento de retina no produce dolor, existen algunos síntomas que alertan de un inminente desprendimiento de retina entre los que se incluyen:
- Aparición súbita de múltiples moscas volantes
- Aparición súbita de flashes o rayos de luz
- Una ¨sombra¨ o cortina sobre una porción del campo visual la cual aumenta de tamaño a medida que el desprendimiento progresa.
Usted debe buscar una evaluación de emergencia inmediata si percibe alguno de estos síntomas.